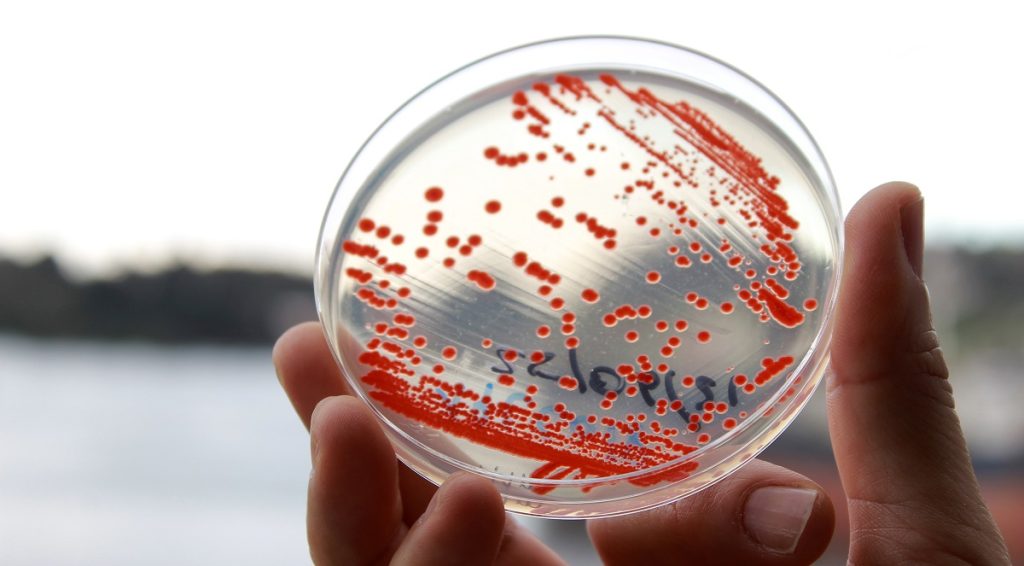

Fortalecer el quehacer científico de la Universidad de Los Lagos como institución pública y contribuir al desarrollo regional articulando capacidades entre la academia y el sector productivo fueron dos principales impactos del proyecto institucional denominado “Fondo I+D+i Universitario Territorial, FIUT-T ULAGOS, destacados por el doctor Óscar Garrido, rector de la Universidad de Los Lagos.
“La Universidad está al servicio del territorio y hoy somos una institución compleja y relevante para el desarrollo regional”, afirmó el rector, con ocasión del lanzamiento del proyecto realizado este martes, en el auditorio universitario ubicado en calle Serena #77, en presencia de autoridades regionales y de la academia universitaria.
En la jornada, se dieron a conocer los alcances y proyecciones del plan estratégico 2026-2035 de la etapa 2 del Fondo I+D+i Universitario Territorial, FIU-T Ulagos, recientemente adjudicado. Proyecto que con recursos por más de 20 mil millones de pesos aportados por el gobierno regional y por la Universidad de Los Lagos, persigue implementar en un horizonte de 10 años, su plan de desarrollo, ejecutar las acciones definidas y asegurar la sostenibilidad de las capacidades de I+D+i+c en la universidad pública y regional.

Se trata de un programa del Ministerio de Ciencia, Tecnología, Conocimiento e Innovación de Chile que financia la generación, mantenimiento y gestión de las capacidades de investigación, desarrollo e innovación (I+D+i) en universidades, con un fuerte enfoque en el desarrollo y competitividad regional y territorial. “La Universidad de Los Lagos tiene el 54% de la matrícula universitaria de la región y el 47,3% de la producción científica teniendo como foco las problemáticas del territorio. Por lo tanto, con este proyecto queremos instalar capacidades estructurales de investigación”, explicó el doctor Hans Richter, director del proyecto FIU-T y vicerrector de Investigación, Innovación y Creación ULagos.
En representación del gobierno regional, la doctora Sandra Orellana, seremi de Ciencia, Tecnología, Conocimiento e Innovación de la Región de Los Lagos, expresó su satisfacción por la adjudicación de este proyecto. “Estamos contentos con lo realizado con la Universidad de Los Lagos hasta ahora. Como representante de la macrozona sur, les deseo mucho éxito con este proyecto porque la Región de Los Lagos necesita conocimiento aplicado, ya que lidera el número de empresas de base científico tecnológica. En este escenario, el FIU-T cobra sentido porque consolida las capacidades de infraestructura, transferencia tecnológica y capital humano a nivel regional”, enfatizó la doctora Orellana.
Anita Dörner, vicerrectora del Campus Puerto Montt, apuntó al fortalecimiento de las capacidades de investigación en la capital regional. “Celebramos la adjudicación de este proyecto con altura de mira, porque estos recursos posibilitarán la disposición de equipamiento científico para realizar un trabajo coordinado e interdisciplinario y asimismo complejizar la investigación que ya realizamos como universidad y como Campus Puerto Montt, contribuyendo también a mejorar el equipamiento en Chinquihue. Felicitamos a los equipos que trabajaron para este logro, elaborando un proyecto de buena calidad, por esto agradecemos a la vicerrectoría de Investigación y a todas las direcciones que contribuyeron”, expresó la vicerrectora.

Noticias relacionadas
Universidad de Chile y Corea del Sur sellan alianza clave en sanidad acuícola
Centro INCAR lanza segunda parte de serie audiovisual «Paper Flash: Ciencia al Instante»
Fundación Chinquihue entregará becas de estudio a hijos e hijas de pescadores artesanales
Sector científico-acuícola lamenta fallecimiento de la Dra. Claudia Venegas y destaca su legado
IFOP fortalece vínculo con pescadores artesanales de Hualaihué
Paper Flash: acuicultura sustentable en cápsulas audiovisuales
Dra. Doris Soto destaca al integrarse a paneles editoriales de revistas internacionales
SalmonChile y WICA impulsan la equidad de género como ventaja competitiva para la salmonicultura
Sernapesca incauta más de 8 toneladas de recursos del mar de origen ilegal en Los Lagos